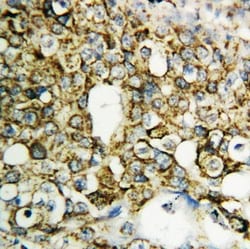
Invitrogen TFPI2 Polyclonal Antibody 100 &mu;g; Unconjugated:Antibodies,

missing translation for 'onlineSavingsMsg'
Learn More
Learn More
Invitrogen™ TFPI2 Polyclonal Antibody


Rabbit Polyclonal Antibody
Brand: Invitrogen™ PA580114
This item is not returnable.
View return policy
Description
Reconstitute with 0.2 mL of distilled water to yield a concentration of 500 μg/mL. Positive Control - WB: MM453 Cell, MM231 Cell, HELA Cell, HT1080 Cell, JURKAT Cell. IHC: Human Mammary Cancer Tissue.
TFPI2 may play a role in the regulation of plasmin-mediated matrix remodeling. It inhibits trypsin, plasmin, factor VIIa/tissue factor and weakly factor Xa. TFPI2 has no effect on thrombin.
Specifications
| TFPI2 | |
| Polyclonal | |
| Unconjugated | |
| TFPI2 | |
| AV000670; Placental protein 5; PP5; PP5/TFPI-2; PP5FLJ21164; REF1; REF-1; retinal pigment epithelium cell factor 1; TFPI2; TFPI-2; TFPI-2REF1; Tissue factor pathway inhibitor 2 | |
| Rabbit | |
| Antigen affinity chromatography | |
| RUO | |
| 7980 | |
| -20°C | |
| Lyophilized |
| Immunohistochemistry (Paraffin), Western Blot | |
| 500 μg/mL | |
| PBS with 5mg BSA and 0.05mg sodium azide, 0.05mg thimerosal | |
| P48307 | |
| TFPI2 | |
| A synthetic peptide corresponding to a sequence in the middle region of human TFPI2 (170-186aa NVTRYYFNPRYRTCDAF). | |
| 100 μg | |
| Primary | |
| Human | |
| Antibody | |
| IgG |
Product Content Correction
Your input is important to us. Please complete this form to provide feedback related to the content on this product.
Product Title
Spot an opportunity for improvement?Share a Content Correction